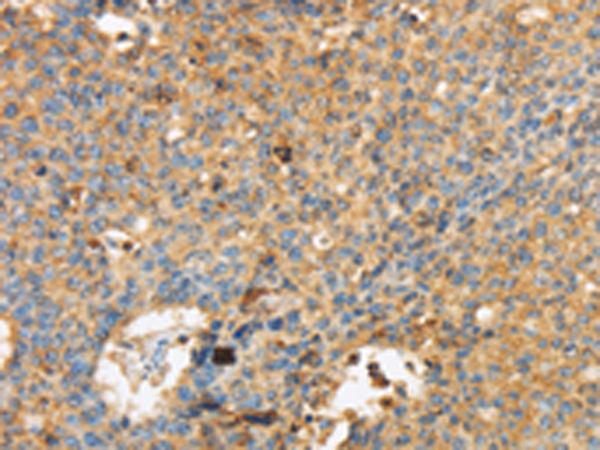

-
分类: 科研抗体货号: P10825别名: ED4; PRR; HIgR; HV1S; HVEC; OFC7; PRR1; PVRR; CD111; PVRL1; PVRR1; SK-12; CLPED1; nectin-1应用: WB反应种属: Human, Mouse
-
分类: 科研抗体货号: P10824别名: DL; ED3; ED5; ED1R; EDA3; HRM1; EDA1R; ECTD10A; ECTD10B; EDA-A1R应用: WB,IHC反应种属: Human, Mouse
-
分类: 科研抗体货号: P10841别名: ERK3; PRKM6; p97MAPK; HsT17250应用: IHC反应种属: Human, Mouse, Rat
-
分类: 科研抗体货号: P10822别名: EAAT4应用: WB,IHC反应种属: Human, Mouse, Rat
-
分类: 科研抗体货号: P10864别名:应用: WB反应种属: Human, Mouse, Rat
-
分类: 科研抗体货号: P10840别名: ERK; p38; p40; p41; ERK2; ERT1; NS13; ERK-2; MAPK2; PRKM1; PRKM2; P42MAPK; p41mapk; p42-MAPK应用: WB,IHC反应种属: Human, Mouse, Rat
-
分类: 科研抗体货号: P10821别名: DCBXA; EAAC1; EAAT3; SCZD18应用: WB,IHC反应种属: Human
-
分类: 科研抗体货号: P10861别名: AIS1, HFH2, VAMAS2, Genesis应用: WB反应种属: Human, Mouse
-
分类: 科研抗体货号: P10839别名: ERK1, ERT2, ERK-1, PRKM3, P44ERK1, P44MAPK, HS44KDAP, HUMKER1A, p44-ERK1, p44-MAPK应用: WB,IHC反应种属: Human
-
分类: 科研抗体货号: P10820别名: DNM应用: WB反应种属: Human, Mouse, Rat

鄂公网安备42018502007531号
鄂公网安备42018502007531号

